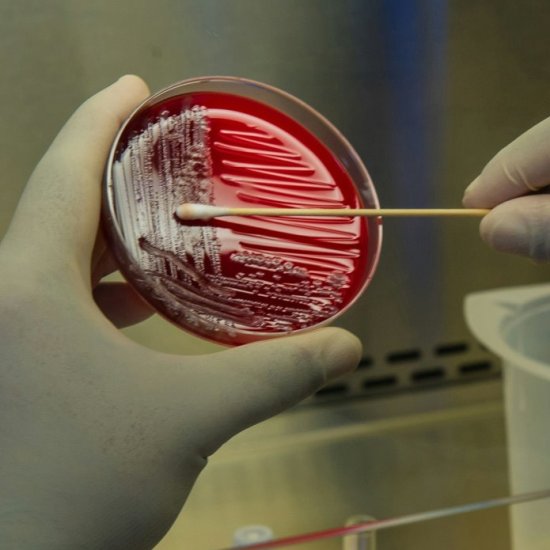

|
|
Is medicine solely about treating patients with the most advanced technology? At JFR 2025, novelist and physician Jean-Christophe Rufin reminded radiologists that healthcare fundamentally remains a human story requiring empathy alongside innovation. The newsletter also features new research uncovering that depression involves more than just the brain, opening possibilities for novel biomarkers. Additionally, experts address challenges in delivering pathology services in resource-constrained settings through AI-based solutions and adapted diagnostic approaches. Enjoy reading!
|
|
 |
Article • Radiology meets literature at JFR 2025
At the 2025 Journées Francophones de Radiologie (JFR), novelist, diplomat, and physician Jean-Christophe Rufin took the stage to remind an audience of radiologists that medicine, at its core, is a human story – one that needs to be told, felt, ... |
News • Appeal for earlier screening approaches
Breast cancer – including aggressive variants – are surprisingly common in younger women, a new study shows. The findings strengthen the case for earlier, risk-tailored screening, the authors say. |
|
News • Manganese MOF nanoparticles
Metal-organic frameworks (MOFs) serve as the basis for a novel type of MRI contrast agent, which the developers hope can outperform current agents while being less toxic for the patient. |
|
News • Exploration of novel biomarkers
Depression is not only a disease of the mind or the brain, a new study finds: a research team has revealed deep connections to abnormalities in the body's overall immune response. |
|
News • New insights on nosocomial pathogen
Pseudomonas aeruginosa, a hospital-acquired bacterium that causes serious infections, can move from the lungs to the gut inside the same patient, raising the risk of sepsis, new research reveals. |
|
Article • On a shoestring budget
Delivering a pathology service in resource-constrained locations and developing countries remains a challenge. Cost is a significant barrier, as is the availability of equipment, trained staff and technical and IT support can also hinder a desire ... |
|
News • Classification of morphology
Researchers have created a system that uses generative AI to study the shape and structure of blood cells, and spot unusual or rare cells that may indicate disease such as leukaemia. |
|
News • Coronary stent failure
A new study shows that complications after stent surgery are more common in individuals with diabetes. The results emphasise the importance of tailoring treatment strategies for this patient group. |
|
News • Proprioception assessment
University of Delaware researchers use robotic testing to spot an often overlooked sensory deficit in stroke survivors – proprioception, the body's ability to sense movement and position. |
|
News • Crisis-resilient hospital design
How can hospital design help adapt to pandemics and climate emergencies? To explore new solutions for smart and sustainable healthcare, experts from Taiwan and Sweden shared their experiences. |
|
News • Benefits for survival and employment
While saving lives remains the primary goal, a new study explores how radiation therapy also helps breast cancer survivors return to work. Policymakers should factor this in, the researchers argue. |
|
News • Standardized assessment criteria
Current scores to assess the severity of illness in ICU patients often fail in international contexts. Researchers now call for a global scoring system based on universally available data. |
|
News • Human-robot symbiosis
Researchers developed an algorithm for personalizing robotic prosthetic devices to optimize the movement of the prosthetic limb and also help a user’s body engage in a more natural walking pattern. |
|
News • In vitro disease models
A major new initiative aims to enable the development of advanced, specific and highly reproducible human in vitro models for greater understanding of disease and the acceleration of new medicines. |
|
News • Attenuation contrast und dark field
Researchers developed an X-ray imaging method capable of revealing hidden features in a single shot. This could advance cancer detection, disease monitoring, security screening and material analysis. |
|
|
|
| |
You are receiving this email because you subscribed to our newsletter on healthcare-in-europe If you don’t want to receive this newsletter anymore, click here to unsubscribe.
Keep up-to-date on the latest news from all hospital-related fields!
Subscribe to our bi-monthly newsletter. Copyright © 2026 mgo fachverlage GmbH & Co. KG.
All rights reserved. E.-C.-Baumann-Straße 5, 95326 Kulmbach, Germany
email: newsletter@european-hospital.com |
|



|
|